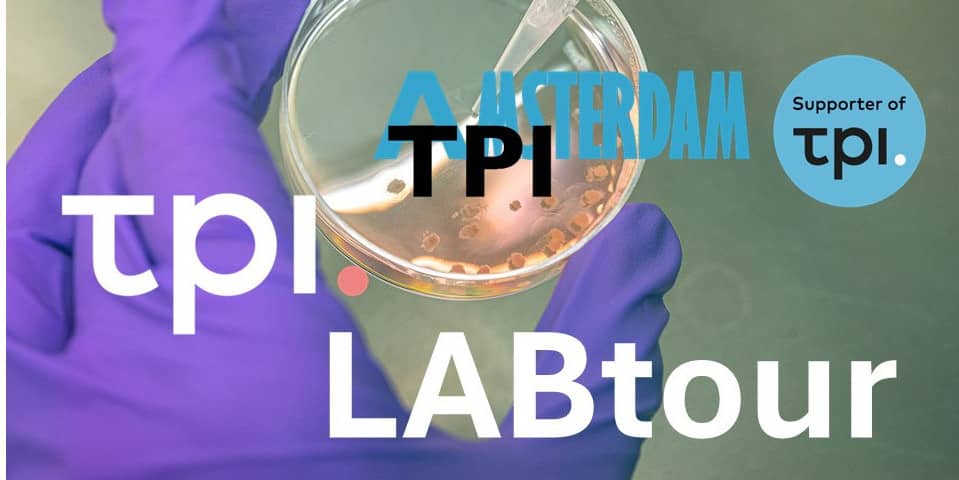

Nieuws

Nieuwsbrief Terugblikken en Vooruitkijken
Terugkijkend zijn de afgelopen maanden intensief geweest voor TPI en alle betrokken partners en belanghebbenden. We hebben met ...
Lees verder
UITNODIGING TPI Labtour Amsterdam 10 november 2025
Ga je mee met de TPI Labtour Amsterdam op 10 november 2025? Ontdek zelf wat proefdiervrije innovaties zijn. En hoe een ...
Lees verder
Ombion Centrum voor Proefdiervrije Biomedische Translatie officieel gelanceerd
Vandaag is het door het Nationaal Groeifonds ondersteunde Centrum voor Proefdiervrije Biomedische Translatie officieel gelanceerd ...
Lees verder
Meer nieuwsberichten
